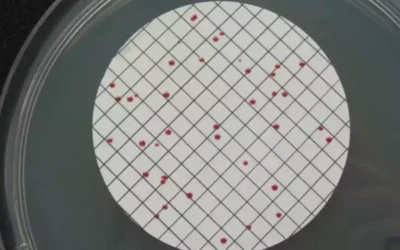
Informes preocupantes sobre la calidad del agua en Illescas

Será a las 16,30 hrs del proximo día 3 de...
Estadísticas del paro en Illescas a lo largo de 2025
En 2025 abandonaron las listas del SEPE un...
Hoy se conmemora el Día Internacional de la Educación
Hoy 24 de Enero, Dia Internacional de la...
La Consejería de Educación creará dos nuevos centros educativos en Illescas
Un centro de Educación Especial y un...
Más de 1,1 millones de euros para remodelar la Plaza de los Leones
Las obras comienzan este próximo lunes día...
4.500 nuevas viviendas construirá Tofiño en Illescas
Asi lo ha comunicado a los medios en el día...
Programación Cultural Illescas 2026. El día 7 se ponen entradas a la venta
La programación cultural 2.026 en Illescas....
La cabalgata de Reyes de Illescas en imágenes
Cabalgata de Reyes 2026. Reportaje Gráfico...
Cabalgata de Reyes Illescas 2.026 Este es el horario y recorrido
Cabalgata de Reyes 2026. Horario y...
Illescas decora Navidad 2025-26. Relación de Ganadores
Relación de los ganadores en el concuros...
Estos son los participantes en Illescas decora Navidad 2025
Los domicilios y lugares de los...
Nuevas tarifas con subida en la autopista AP-41
Nuevas subidas en las autopistas y autovias...
Días festivos y calendario laboral en Illescas 2.026
Calendario Laboral y relación días festivos...
Investigador de Illescas publica un estudio científico sobre la fibromialgia
Articulo publicado en la prestigiosa...
Informes preocupantes sobre la calidad del agua en Illescas
Informes negativos sobre el estado de...